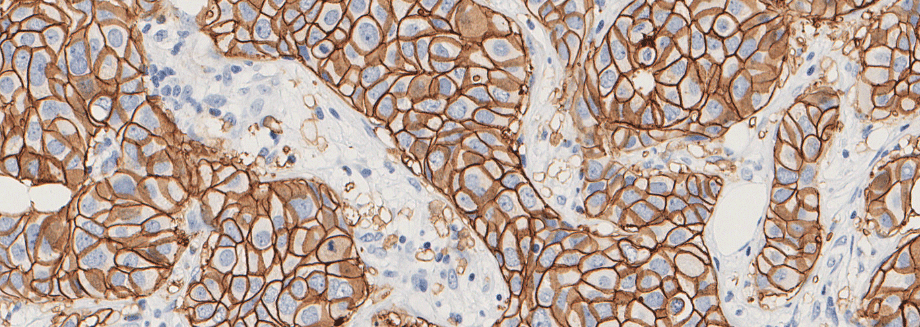

Agilent announces end-to-end digital pathology workflow solution for USCAP 2023
Agilent Technologies Inc. (NYSE: A) announced today a highly-anticipated end-to-end solution for digital pathology that brings together best-in-class products from Agilent, Visiopharm, Proscia®, and Hamamatsu Photonics K.K. The announcement coincides with the USCAP 112th Annual Meeting held March 11-16 at the New Orleans Ernest N. Morial Convention Center in New Orleans, Louisiana.
The increasing prevalence of chronic conditions is predicted to intensify the urgency of pathologists seeking to adopt innovative digital pathology solutions to improve existing patient diagnostic imaging methods and reduce the high cost associated with traditional diagnostics. Technological advances in the past decade and the numerous benefits of digital pathology are driving the practice to become widely adopted.
Agilent and Visiopharm have collaborated since 2020, developing an integrated solution comprising Visiopharm’s portfolio of leading artificial intelligence (AI)-driven precision pathology software and Agilent’s automated pathology staining solutions. The collaboration also includes a distribution agreement, initially in Europe but now expanded to include the US and Canada. Agilent and Visiopharm have also broadened their development services to include digital pathology applications that will increasingly benefit the global pharmaceutical industry by providing access to Visiopharm’s AI capabilities to deliver innovative, high-quality companion diagnostics.
“Agilent has meticulously and diligently been working toward the development of a complete end-to-end digital pathology solution to help pathology labs increase efficiency, clinical utility, quality control, and ultimately patient care,” said Lou Welebob, vice president and general manager of Agilent’s Pathology Division, Diagnostics and Genomics Group.
“Our objective was to work with industry innovators, starting with Visiopharm as our initial partner. We are now excited to announce that we have expanded our offering through the addition of two other partners Proscia and Hamamatsu, in this fast-growing digital pathology space,” Welebob added.
“Together, we have enabled pathologists to improve patient care through the integration of our AI-driven precision pathology software and Agilent’s automated staining solutions,” said Michael Grunkin, CEO of Visiopharm. “We are delighted to further extend our partnership in this emerging era of personalized medicine.”
The recent announcements include Proscia, a leader in digital pathology solutions, and Hamamatsu, a leading provider of whole slide imaging systems. The technology combination of Agilent, Visiopharm, Proscia, and Hamamatsu strengthens the development of an open and agnostic end-to-end digital pathology solution with the vision of accelerating breakthroughs in precision medicine.
USCAP attendees are invited to visit Agilent’s exhibition booth #129 and learn about these partnerships, products, and solutions. Agilent is also bringing together partners and industry thought leaders to discuss the future of cancer care and how an open, agnostic system can dramatically change the future of cancer care. Presenters will include Alan Byrne, Principal Global Product Manager, Digital Pathology, Agilent Technologies; David West, CEO, Proscia; Saira Shah, M.D., Physician Pathologist and Breast Consultant Pathologist, Quest Diagnostics; Martin Kristensson, Senior Vice President, Global Clinical Sales, Visiopharm; and Giovanni Lujan, M.D., Director of Digital and Computational Pathology, Ohio State University. Additional information about this event will be available at the Agilent booth.
About Agilent Technologies
Agilent Technologies Inc. (NYSE: A) is a global leader in the life sciences, diagnostics, and applied chemical markets, delivering insight and innovation that advance the quality of life. Agilent’s full range of solutions includes instruments, software, services, and expertise that provide trusted answers to our customers’ most challenging questions. The company generated revenue of $6.85 billion in fiscal 2022 and employs 18,000 people worldwide. Information about Agilent is available at www.agilent.com. To receive the latest Agilent news, please subscribe to the Agilent Newsroom. Follow Agilent on LinkedIn and Facebook.
About Visiopharm
Visiopharm® is a leading provider of AI-driven precision pathology software for research and diagnostics. In research, it is a technology leader providing tools that help scientists, pathologists, and image analysis experts produce accurate data for all types of tissue-based research. In diagnostics, it is a world leader within clinical applications, with no less than eight diagnostic algorithms cleared under IVDR for EU customers. These applications provide diagnostic decision support and quality assurance and can be easily activated and integrated into existing lab workflows.
Founded in 2002, Visiopharm is privately owned and operates internationally with over 750 customer accounts in more than 40 countries. The company’s headquarters are located in Denmark’s Medicon Valley, with offices in Sweden, the UK, Germany, the Netherlands, and the United States, and local representation in France and China.
For enquiries:
Naomi Goumillout
Agilent Technologies
+1.781.266.2819
naomi.goumillout@agilent.com
Johanne Louise Brændgaard
Chief Marketing Officer
jlb@visiopharm.com



